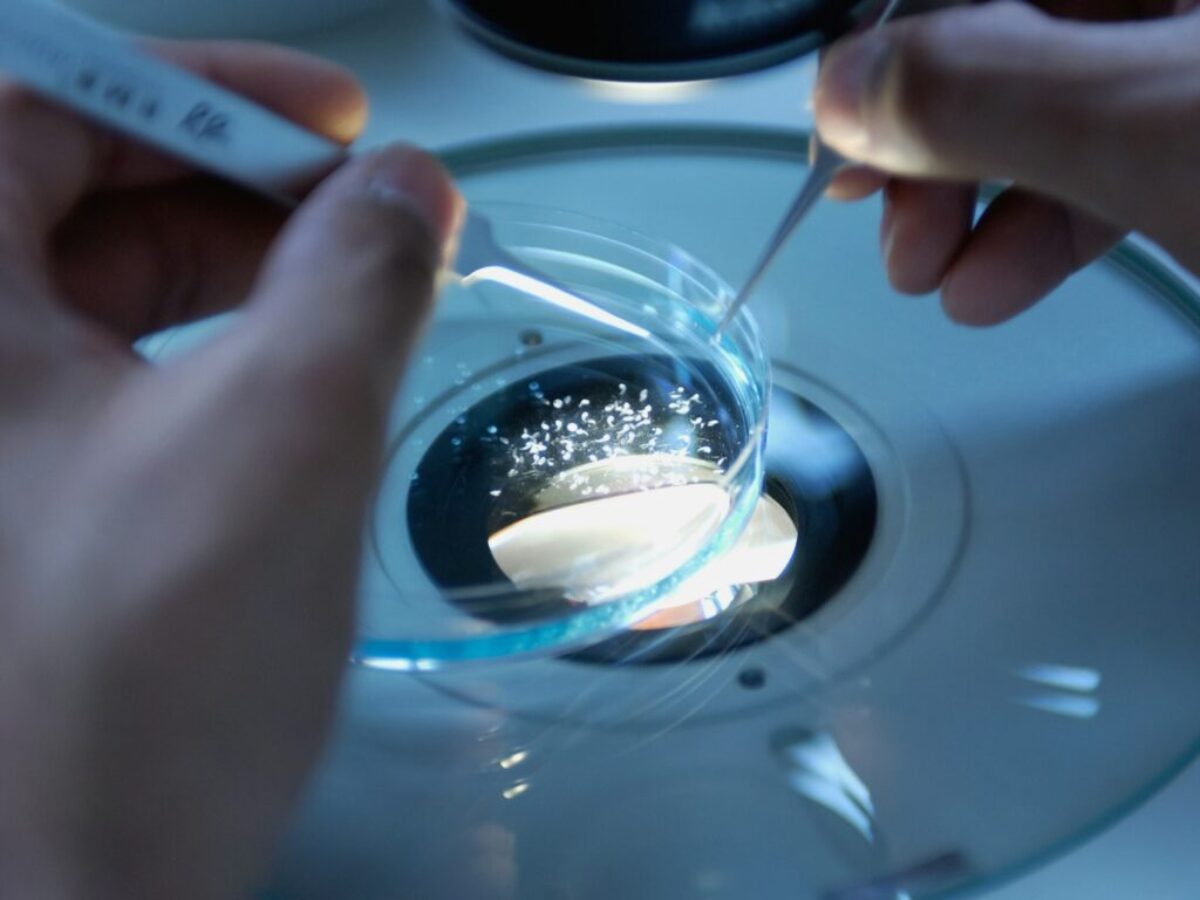
a close up of a person holding a toothbrush

Vědcům se podařilo vypěstovat model lidského embryonálního mozku a míchy
Vědcům se poprvé podařilo vypěstovat v laboratoři malý trojrozměrný model nejranějších vývojových stadií lidského centrálního nervového systému. Nový model je typem organoidu – miniaturního 3D modelu, který je vyroben z živých tkání a je navržen tak, aby napodoboval jedinečné složitosti lidských orgánů.
Takové miniaturní orgány mají zachytit lidskou biologii přesněji než tradiční zvířecí modely, což může být využito při objevování a vývoji léčiv. Tyto modely by například mohly výzkumníkům pomoci přesněji předpovědět, které léky ve výzkumném procesu by mohly být úspěšné u lidí, a ne pouze na laboratorních myších.
V posledních letech byla vyvinuta celá řada organoidů, od malých bijících srdcí až po miniaturní varlata. Kromě toho byly již dříve pěstovány mozkové organoidy, ale vědci, kteří stojí za novým modelem, tvrdí, že je to poprvé, kdy se podařilo v laboratoři napodobit všechny tři části embryonálního mozku a míchy, uvádí Live Science.
Mini model of human embryonic brain and spinal cord grown in lab https://t.co/Gyd6eIccKN
— Live Science (@LiveScience) February 28, 2024
Nový model byl vytvořen pomocí lidských pluripotentních kmenových buněk, tedy buněk, které mají potenciál stát se jakýmkoli typem buněk v těle. Nejprve byly kmenové buňky přiměny, aby vytvořily řadu dlouhou asi 4,39 cm a širokou 0,018 cm. To se podobalo tvaru a velikosti neurální trubice – rané struktury, z níž vzniká mozek a mícha, která by se měla nacházet u čtyřtýdenního lidského embrya.
Tým poté vložil tuto řadu buněk do takzvaného mikrofluidního zařízení obsahujícího spoustu malých kanálků. Prostřednictvím těchto kanálků vystavili buňky různým chemickým látkám, čímž je přiměli k růstu a vytvoření 3D struktury, která se podobala rané centrální nervové soustavě.
Během 40 dnů se buňky v organoidu samy uspořádaly do struktur, které se podobaly raným stadiím vývoje mozku a míchy u lidského embrya. Vznikly tak struktury známé jako přední, střední a zadní mozek a také mícha.
zdroj: Live Science
Nejnovější články
- Jeden nespokojený senior může zablokovat stavbu celého satelitního městečka o několika domech
- Kalifornie testuje autobusy s rychlostí 225 km/h. Pro svou zběsilou jízdu budou mít vlastní pruh na dálnici
- Některé České restaurace trestají nedojedená jídla poplatkem. Kdo nedojí, připlatí si
- Cyklistický airbag může být rozhodujícím prvkem pro záchranu života. Objevují se hlasy pro jeho povinné zavedení
- Ukrajina tak dlouho žádala USA o zbraně dlouhého doletu, až se je naučila vyrábět sama
- Psychologie říká, že lidé, kteří dosáhnou 70 let a uvědomí si, že je jejich děti již nepotřebují, mohou pociťovat hluboký dopad na své duševní zdraví
- Zpráva evropských úřadů potvrzuje: hrozny, jahody a pomeranče jsou ovoce nejvíce kontaminovány pesticidy
- Kbelík a mop mají své dny sečteny: odborníci na úklid sdílejí stejný názor a v roce 2026 se přiklánějí k jeho vylepšené verzi
- Blíží se úplné zatmění slunce: Dočkáme se ho v létě a bude to nádherná podívaná
- Je konec: Legendární švédská automobilka po 75 letech končí prodejem posledních vyrobených aut